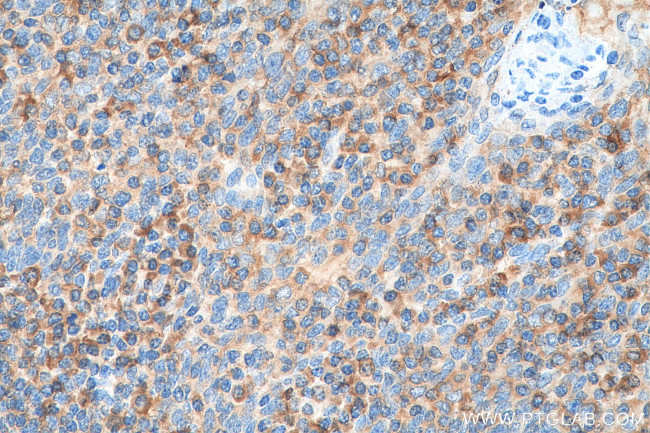
ValRS Antibody in Immunohistochemistry (Paraffin) (IHC (P))

Search
Proteintech
ValRS Polyclonal Antibody
{{$productOrderCtrl.translations['antibody.pdp.commerceCard.promotion.promotions']}}
{{$productOrderCtrl.translations['antibody.pdp.commerceCard.promotion.viewpromo']}}
{{$productOrderCtrl.translations['antibody.pdp.commerceCard.promotion.promocode']}}: {{promo.promoCode}} {{promo.promoTitle}} {{promo.promoDescription}}. {{$productOrderCtrl.translations['antibody.pdp.commerceCard.promotion.learnmore']}}
产品信息
15931-1-AP
种属反应
宿主/亚型
分类
类型
抗原
偶联物
形式
浓度
规格
纯化类型
保存液
内含物
保存条件
运输条件
产品详细信息
Immunogen sequence: ECGTDALRF GLCAYMSQGR DINLDVNRIL GYRHFCNKLW NATKFALRGL GKGFVPSPTS QPGGHESLVD RWIRSRLTEA VRLSNQGFQA YDFPAVTTAQ YSFWLYELCD VYLECLKPVL NGVDQVAAEC ARQTLYTCLD VGLRLLSPFM PFVTEELFQR LPRRMPQAPP SLCVTPYPEP SECSWKDPEA EAALELALSI TRAVRSLRAD YNLTRIRPDC FLEVADEATG ALASAVSGYV QALASAGVVA VLALGAPAPQ GCAVALASDR CSIHLQLQGL VDPARELGKL QAKRVEAQRQ AQRLRERRAA SGYPVKVPLE VQEADEAKLQ QTEAELRKVD EAIALFQKML (916-1264 aa encoded by BC012808)
靶标信息
Aminoacyl-tRNA synthetases catalyze the aminoacylation of tRNA by their cognate amino acid. Because of their central role in linking amino acids with nucleotide triplets contained in tRNAs, aminoacyl-tRNA synthetases are thought to be among the first proteins that appeared in evolution. This protein belongs to the class-I aminoacyl-tRNA synthetase family and is located in the class III region of the major histocompatibility complex.
仅用于科研。不用于诊断过程。未经明确授权不得转售。
生物信息学
蛋白别名: EC 6.1.1.9; Protein G7a; unnamed protein product; valine tRNA ligase 1, cytoplasmic; Valine--tRNA ligase; ValRS; valyl trna synthetase; Valyl-tRNA synthetase; valyl-tRNA synthetase 2
基因别名: Bat6; D17H6S56E; G7A; NDMSCA; TrsVal; VARS; VARS1; VARS2
UniProt ID: (Human) P26640, (Rat) Q04462, (Mouse) Q9Z1Q9
Entrez Gene ID: (Human) 7407, (Rat) 25009, (Mouse) 22321